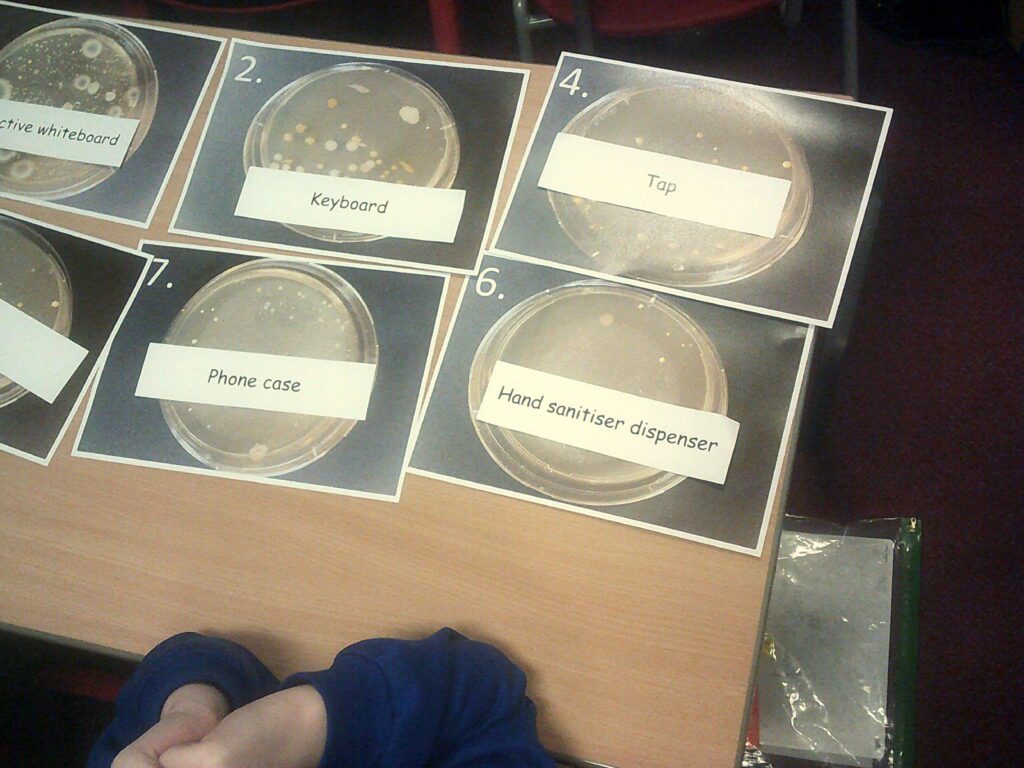
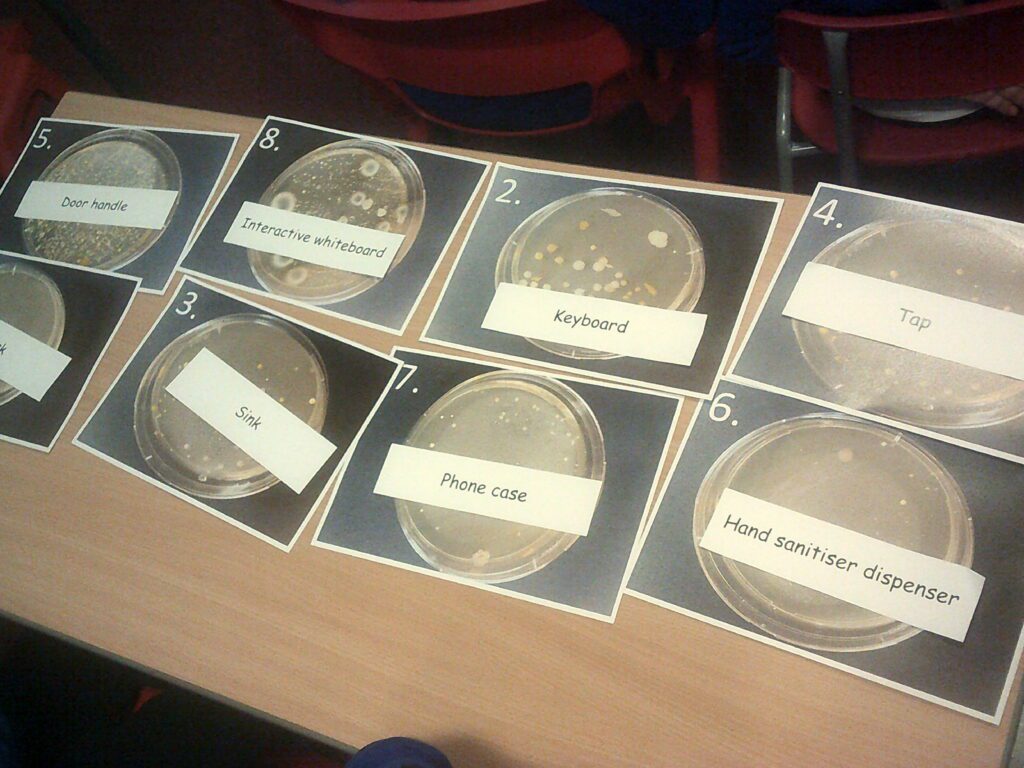

Curling…









Fencing…











Climbing Wall
As part of health week, we got the chance to brave the climbing wall! Look at us go…
































Coal to Goals at The Beacon of Light…
Year 6 went to the old site of The Wearmouth Colliery where the Stadium of Light now sits. We learned all about the history of the area and our mining heritage-we had the best day! We did some sports since the site is now a sporting hub, we met a gentleman with a heritage of mining and looked at how the SAFC badge has changed over the years to incorporate Sunderland’s rich heritage into it.









































Releasing our beautiful butterflies…




SAT’s trip treat to the beach…















Nissan’s Eco School…

















































We read with the younger children in school for World Book Day!















DT Mayan Masks…
















During Children’s Mental Health Week we connected with Nursery children…
















Nissan’s Monozukuri Caravan Trip
Mrs Smith’s Literacy Group and Miss Slater’s class went to Nissan to learn about what happens at the plant, its origins and some of the amazing technology they have. We all went and now most of us want to work there when we are older-it was amazing!












































Children in Need…
Year 6 organised and ran this year’s Children in Need fair fir the whole school to enjoy-from stalls, raffle and name the teddy to decorate a biscuit-we had it and it was amazing!





















A visit from the Dogs Trust…
Rachel from Dogs Trust came in to teach us how to stay safe around dogs-we learned lots of things to keep us safe and ensure dogs are happy too-it was very informative and fun as we did some drama and acted out different scenarios!


















Great North Museum Trip for Evolution and inheritance…












Redhouse Academy Visit…





























































































Bugs ‘N’ Stuff…




























































































































MacMillan Coffee Morning…
It was our turn as the new year 6’s to organise and host a coffee morning to raise money for Macmillan Cancer Care. We did an amazing job and everyone had a great time-we raised over £300!
































Live Theatre Visit…
Half of us went to The Empire Theatre to take part in Live Tales where we learned all about the different aspects of a play. We used our imaginations to create a script, we acted out scripts that had conflict and some without and we did lots of breathing and action movements-we had an amazing day!






























Miss Young and Mr Marley from Redhouse Comprehensive joined us today for Science Week. We looked at bacteria that the staff had grown from swabs from different places around their school. We knew bacteria grows because it is a living micro-organism.
We looked at pictures from petri dishes grown from the different places and tried to match them up with their labels-we were shocked to see the phone case and key board produced the most! The taps and sinks in the toilets produced the least and this shocked (and reassured) us too!
We then played a science version of Among Us to explore how fast bacteria and infection could spread. Two anonymous people were infected and we had to share solution from our boiling tubes with the rest of the class. We then added iodine to our solution and black meant we were infected, brown meant no infection. We were shocked to see how quickly the infection had spread! We were able to narrow the suspects to 4 of us but couldn’t identify the actual infectious! We had a great session and cannot wait to get to comp to do even more exciting things!

Investigating beaks and evolution…
As part of our evolution and inheritance topic we have looked at beaks from a range of birds in South America. We looked at a dip netting beak (a spoon), a coniferous seed eating beak (scissors) and an insect catching beak (tweezers). We had a range of foods too: marbles (to represent hard nuts and seeds), cocktail sticks (stick insects), elastic bands (worms), marshmallows (berries and peas (soft fruits). We all chose a type of beak and predicted the foods we would be able to pick up-we had great fun and there were a few surprises too!

















Santa Dash…
Chase and catch Santa? Yes please! We chased but we didn’t catch. However, we had loads of fun!
















Our trip to the pantomime…
Year 6 went to see Sleeping Beauty at the Tyne Theatre in Newcastle-oh yes we did! It was AMAZING and so were we! We all had the best time as we laughed, screamed, booed and cheered-it was wonderful!







Guyanese food tasting…
Abigail, Tiffany and their family sourced and prepared a delicious food tasting for us today. We tried a range of foods and drinks and had an amazing afternoon-thank you to the Luckham family!
















































It’s beginning to look at lot like Christmas!
We put our tree up today and there is an amazing buzz around the class on the build up to the festivities!










Investigating yeast in our Micro-organisms topic…
We did an investigation linked to yeast to see what it preferred to eat so we could see a reaction actually happening. We conducted a fair test and made our predictions then watched in awe as we saw yeast produce carbon dioxide as it ate sugar (its favourite food). We had to weigh, measure and observe and we had great fun!















Amazing Homework…
We aren’t content working our socks off for 6 hours a day at school-we work our socks off at home too as we are so enthused by our in school learning. Here are some wonderful examples from our Remembrance learning and our Jigsaw too-well done Tiffany, Kadie and Alanah!



Column Addition with Exchanging…
We used Base 10 to really understand what happens when we exchange 1’s for a ten or 10’s for a hundred and 100’s for a thousand-we are flying with the method now!





Micro-organisms…
We have learned a lot about micro-organisms and we have started an investigation that shows us what they look like and how fast they grow in different conditions. We rubbed our hands (and bacteria) all over some bread and left it in 3 different places (a warm place, a cool place and a dark place). We have made predictions and cannot wait to see it start to grow! We also looked at how fast germs and microbes can be spread using green paint and a little imagination!







Our Kind Fair…
COVID may have stopped us having the whole school together in the hall to celebrate the start of Anti Bullying Week 2021 but it didn’t stop year 6 (and Eden Sampson’s mam) from making crochet bees, bookmarks, key rings and friendship bracelets! We sold them (socially distanced of course) around school and the response was amazing! Thank you to everyone who made, sold and bought something!






A special Treat…
Kadie Wilson made us biscuits from scratch this weekend and they were delicious! They were very much appreciated and put smiles on our faces-thank you Kadie! What a lovely Monday morning surprise!

Bugs ‘n’ Stuff Visit…
We had a visit from Guy at Bugs ‘n’ Stuff to look at a range of South American animals. We were visited by: a leaf insect, a stick insect, a Mexican Milk snake, a cockroach, poisoned dart frog, marine toad, Golden Orb spider and a tarantula! They were amazing!































































































Outdoor Learning…
We continued our learning outside of the classroom this week and started with a focus on play. We looked at the animals on the yard and used the knowledge we have gained when classifying animals to group accordingly and then give detailed descriptions of the features of the different groups. We were also encouraged to play with toys we wouldn’t think too as “we are too grown up” and we had a great time!








We also went on a hunt for natural materials and then described the features and characteristics of different animals as we created our own from the natural materials we collected. Our curriculum is all about revisiting and what a great way to commit knowledge to our long-term memory. We had so much fun we didn’t realise we were learning!







































Guess My Number in maths…
Mrs Smith’s maths group had great fun today playing the maths version of Guess Who! Each stand has a series of numbers and the children have to ask questions to find their opponent’s number-we used questions such as: is it odd? Is it a multiple of 10? Is the hundreds digit a multiple of 4 and 12? We learned so much vocabulary and really had to think about our questions (and answers) it was so much fun too!






Class 17’s assembly for parents and then the whole school…
Today is was the turn of class 17 to show their parents what they have been learning about since September. They then showed the whole school and were amazing! They even had an art gallery to showcase their brilliant art work! Well done class 17!
















Year 6 acting class…
Ross Wylie from The Northern Stage in Newcastle gave us an acting masterclass over Zoom! We played games, explored different characters and even got to act in front of the camera!















Paired editing…
Today some of us worked in pairs to edit our persuasive speeches. We read them to each other then worked collaboratively to improve each other’s giving constructive feedback and areas that could be improved. We worked brilliantly together and the results were excellent!









Tag Rugby
A Falcon visited us today and showed us some of his Newcastle Falcon rugby skills-it was amazing!




















Show Club…
Year 6 children lead and support the younger children in school during Show Club (one of our after school clubs led by our theatrical expert, Miss Hetherington. The children get to build their confidence, keep fit and have fun whilst learning dance routines and songs from famous musicals…











Art based on animals from the Amazon Rainforest…
It was a tale of 2 classes today in art. Mrs. Smith’s class were looking at proportion when sketching so used part of a picture to help us get the features of our animals in proportion. Mrs. Ellison’s class were experimenting with pastilles to create tone and texture on their animals. I’m sure you’ll agree the results from both classes were amazing!



















Choosing our House Captains and Vice Captains…
Today was a very exciting day! Year 6 got to vote for the captains and vice captains for each of our 6 houses in school. Those who wanted to be considered gave a speech outlining the strengths and qualities they would bring to the role and then we had a secret vote so we didn’t influence each other’s choices. We are so proud of everyone who nominated themselves-some of the children really took themselves out of their comfort zones-well done all of you!









Presenting your Captains and Vice Captains…
Marsden Rock: Captain-Tiffany, Vice Captain-Vincent
Spire Bridge: Captain-Jayden, Vice Captain-Abby
Angel of The North: captain-Archie
Roker Pier: Captain-Abigail, Vice Captain-Delaney
Souter Lighthouse: Captain-Mercedes, Vice Captain-Landi
Penshaw Monument: Captain-Sophia, Vice Captain-Harry
We cannot wait to see what you bring to each of your houses this year-well done everyone!






Glockenspiels…
We had our first music lesson of this academic year today, learning the glockenspiel with Mrs Simmonds. We played notes A and G along to Happy by Pharrell Williams. Everyone certainly was happy and amazing too!









Get Caught Reading…
















